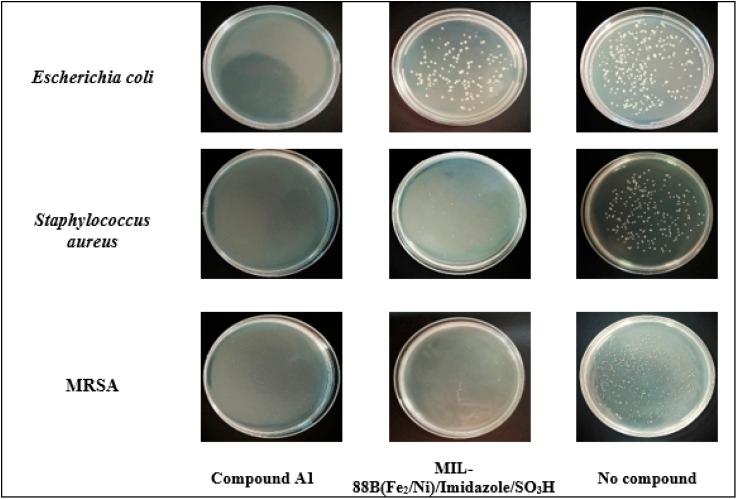
https://cdn.ncbi.nlm.nih.gov/pmc/blobs/6090/11815556/4bf5080f50d7/d4ra07521h-f10.jpg

一种带有磺酸标签的双金属金属有机框架化合物在制备生物活性烟腈协同乙烯型异头碳基氧化反应中的合成与应用
Synthesis and application of a bimetallic-MOFs with sulfonic acid tags in preparation of biologically active nicotinonitriles cooperative vinylogous anomeric-based oxidation.
作者信息
Rasooll Milad Mohammadi, Ahmadi Hossein, Sepehrmansourie Hassan, Zolfigol Mohammad Ali, Ghytasranjbar Elaheh, Mohammadzadeh Abdolmajid
机构信息
Department of Organic Chemistry, Faculty of Chemistry and Petroleum Sciences, Bu-Ali Sina University Hamedan 6517838683 Iran
Faculty of Converging Science and Technologies, University of Qom Qom 37185-359 Iran
出版信息
RSC Adv. 2025 Feb 12;15(6):4636-4651. doi: 10.1039/d4ra07521h. eCollection 2025 Feb 6.
Bimetallic-organic frameworks (bimetallic-MOFs) have broad capabilities owing to the synergistic properties of two metals in a single structure. In this regard, we prepared a bimetallic-MOF containing iron (Fe) and nickel (Ni) metals. The prepared bimetallic-MOF was functionalized with sulfonic acid groups a post-modification method. Thus, a new acidic catalyst with special abilities was prepared. The physicochemical properties of the bimetallic-MOF containing sulfonic acid groups were investigated through FT-IR, SEM, BET/BJH, XRD, EDS, elemental mapping and TGA/DTG analyses. According to the acidic active sites in the structure of the presented catalyst, we investigated the performance of this catalyst in the synthesis of nicotinonitrile derivatives. The structure of the products was also confirmed using melting point, FT-IR, HR-mass, H-NMR, and C-NMR analyses. Moreover, the antibacterial properties of the synthesized product and MIL-88B(Fe/Ni)/imidazole/SOH were investigated, and results showed satisfactory antibacterial properties of these compounds against Gram-positive and Gram-negative bacteria.
双金属有机框架材料(bimetallic-MOFs)由于单一结构中两种金属的协同特性而具有广泛的性能。在这方面,我们制备了一种包含铁(Fe)和镍(Ni)金属的双金属MOF。通过后修饰方法,用磺酸基团对制备的双金属MOF进行功能化。因此,制备了一种具有特殊性能的新型酸性催化剂。通过傅里叶变换红外光谱(FT-IR)、扫描电子显微镜(SEM)、比表面积分析仪/巴雷特-乔伊纳-哈尔德(BET/BJH)、X射线衍射(XRD)、能谱分析(EDS)、元素映射和热重分析/微商热重分析(TGA/DTG)等方法对含磺酸基团的双金属MOF的物理化学性质进行了研究。根据所制备催化剂结构中的酸性活性位点,我们研究了该催化剂在烟腈衍生物合成中的性能。还通过熔点、FT-IR、高分辨质谱(HR-mass)、氢核磁共振(H-NMR)和碳核磁共振(C-NMR)分析对产物结构进行了确认。此外,还研究了合成产物和MIL-88B(Fe/Ni)/咪唑/磺酸(SOH)的抗菌性能,结果表明这些化合物对革兰氏阳性菌和革兰氏阴性菌具有令人满意的抗菌性能。